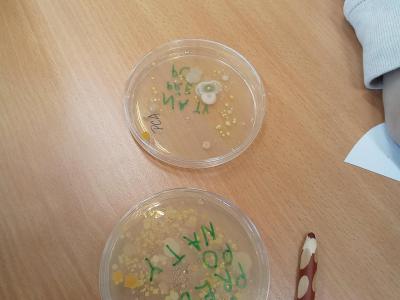

Naše škola zpracovává v souvislosti s využitím webových stránek pouze taková cookies, která jsou nezbytně nutná pro zajištění provozu webových stránek a internetových služeb, a u kterých není nutno získat souhlas uživatele webu (technické a relační cookies). Pravidla cookies